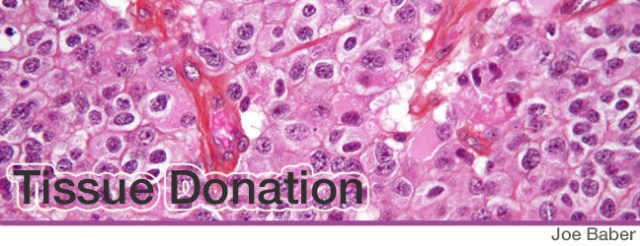
TissueDonation

Progress, unfortunately is sometimes forged from the fires of pain mixed with strength, courage, passion and determination. Nancy Goodman has such a story. Nancy made a donation that no parent ever wants to give.
“My son, Jacob, was a beautiful, happy, kind, funny, serious, inquisitive, articulate, contemplative, exuberant, talkative boy. He loved all sports, playing keyboards and vocals in rock bands, spending time with his little brother, Ben. He wanted to be a good kid. When Jacob was 8, he was diagnosed with medulloblastoma.
Jacob’s disease was unresponsive to treatment and burdened him with terrible impairments. Jacob struggled with brain cancer for two years. Finally, on January 16, 2009, at age 10, he lost that struggle.”
“One step we took that has brought us great comfort was to request an autopsy tissue donation. We hope that through this donation, we might one day prevent another child from suffering Jacob’s fate. Tumor tissue is scarce and much research for pediatric brain cancer is delayed or never undertaken because there isn’t enough tissue available. Tissue donation is one of the few positive steps we can take during this trying time. And it is a contribution that only we, the parents of children with brain cancer, can make.”
“Jacob’s tissue was sent to several pediatric cancer researchers. We are happy to report that even this one step has promoted scientific understanding of pediatric brain cancer. One research team reported a new observation as a result of a genetic analysis of Jacob’s primary and metastasized tumor tissue. Another research team was successful in developing the first xenograft autopsy tissue mouse model from autopsy materials.”
Today, the lightning fast technology coming on board in genomic research for brain cancer is being severely slowed down due to lack of tissue.
So that researchers can obtain the tissue they desperately need, Nancy founded KidsVCancer (www.kidsvcancer.org) and is working to make autopsy tissue donations more common. If you are a doctor, parent or caregiver and would like more information, please contact KidsVCancer and they can assist you. If your organization would like to help Nancy promote tissue donations, KidsVCancer would love to talk to you.
Five year old Dylan Jewett was diagnosed with a diffuse intrinsic pontine glioma (DIPG) on November 15, 2008, Danah, his mother says of her decision, “I know the decision to
donate autopsy brain-tumor tissue is the hardest decision a parent will ever have to make. No parent should have to make this choice. But, if your child loses a battle with brain cancer here on earth, please consider donating his or her tumor for research. The donation will be used to save another child’s life. As awful as it is for us to have to say goodbye to our beloved child, at least we can help another child be healed through the decision to donate.”
Nancy did not stop at trying to improve tissue donations. She also championed the Creating Hope Act through Congress. The act gives a real incentive for drug companies to produce a child specific drug.
Nancy said, “Jacob died on a Friday, and Saturday morning I put my laptop on the dining room table and started working.” Jacob’s friends and other young cancer survivors lobbied members of Congress for passage of the Creating Hope Act. Other families of children with cancer joined in.
Dr. Henry Friedman, a leading Duke University Medical Center pediatric neuro-oncologist remarked, “The reason that companies don’t make pediatric drugs is all market force driven. Companies have an obligation to their shareholders to make money. The pediatric diseases by and large are such low numbers. The incentive to make pediatric drugs is very small.”
The Hope Act works by offering vouchers as “big fat carrots” as Nancy likes to describe
them. “The vouchers offered to drug companies come with rights to a speedier FDA review of another drug they are trying to get to market, possibly a blockbuster drug, and it does not require taxpayer funding.” If a company can shave 6 months off the normal review time, it could be a huge financial gain for them.
The Creating Hope Act was signed into law on July 9, 2012 and today Nancy is actively
working with the FDA to get the full benefit of the new incentive for drug companies.
We are looking forward to the day that Nancy Goodman says, “Here is the first childhood cancer drug as a result of the Creating Hope Act.” When that happens, it will serve as an example to other companies and we will be well on the way to having more and more effective drugs to fight childhood cancers.
Photo: Nancy’s daughter chases President Obama around his office on the day the act was signed into law.
Recent Update: Recently, Nancy Goodman gave some very encouraging news. At least four companies have applied for Creating Hope Vouchers. Three vouchers have already been authorized and the FDA is reviewing other applications. In February 2014, Vimizim was granted priority review. It was the first drug to receive the Rare Pediatric Disease Priority Review Voucher – a provision that aims to encourage development of new drugs and biologics for the prevention and treatment of rare pediatric diseases. Vimizim will be used to treat Morquio A syndrome which is a rare, autosomal recessive lysosomal storage disease caused by a deficiency in N-acetylgalactosamine-6-sulfate sulfatase (GALNS). Vimizim is intended to replace the missing GALNS enzyme involved in an important metabolic pathway. Absence of this enzyme leads to problems with bone development, growth and mobility. There are approximately 800 patients with Morquio A syndrome in the United States. Patient populations of this size usually get little attention from drug developers. Two other drugs, one for neuroblastoma were also awarded vouchers.
A little known sunset provision was included in the Creating Hope Act which said that the Act would expire one year after the third voucher was issued. That means Creating Hope will expire on March 17, 2016. We can not let this important and valuable drug producing legislation just die. Please help re-aurthorize Creating Hope by clicking here: 
Author: Joe Baber